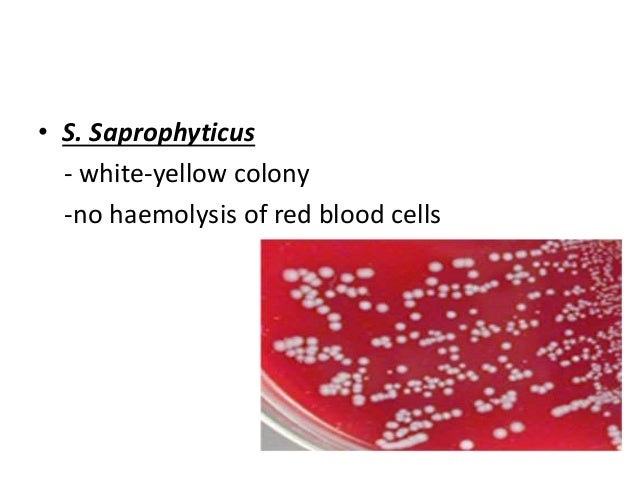

Строение стафилококка: как этот микроорганизм влияет на здоровье






















:max_bytes(150000):strip_icc()/staph_aureus-5b7f28e346e0fb0050c89547.jpg)

:quality(85)/cloudfront-us-east-1.images.arcpublishing.com/infobae/OGQSKNSIPBEHJDUNCRKGB3LLMA.jpg)















Друзья, добро пожаловать в нашу галерею! Визуальные образы говорят громче слов, и наша коллекция картинок создана, чтобы вдохновлять вас и рассказывать уникальные истории. Каждая фотография и иллюстрация — это маленькое окно в мир идей, эмоций и красоты. На нашем сайте вы найдете моменты, запечатленные в кадре, которые останутся с вами навсегда, художественные интерпретации, которые пробуждают воображение и создают новое восприятие знакомых вам явлений. Наслаждайтесь просмотром, черпайте вдохновение и делитесь любимыми находками!